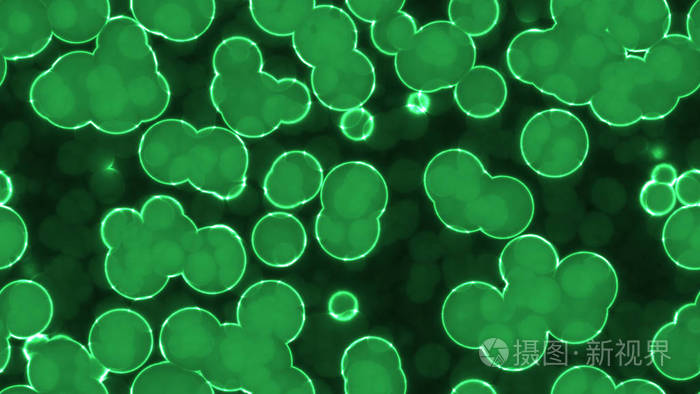
7680*4320px发票合同问题/闪耀发光闪光光泽荧光查看作者其他作品查看

闪光细胞

闪光细胞:指炎症感染过程中发生脂肪变性的一种多核白细胞.
图片尺寸490x326
显微镜下的尿液闪光细胞
图片尺寸1236x772
复合粒细胞?闪光细胞?吞噬细胞?求解,一般遇到这样的细胞都怎么报?
图片尺寸720x960
红色发光发光细胞无缝背景纹理
图片尺寸700x394
尿液分析——尿液显微镜中的世界
图片尺寸2000x2000
白细胞
图片尺寸650x488
一种荧光试剂,能让癌干细胞"现身"
图片尺寸400x300
闪光单卵细胞球get
图片尺寸961x720
细胞荧光染色照片
图片尺寸500x396
skbr3细胞长出触角
图片尺寸3024x4032
bioss讲堂照亮您的细胞多彩荧光助您发表高分文章
图片尺寸708x512
来回调节细准焦螺旋时,这种"闪光"的折光性表现更明显,就像夜空中一闪
图片尺寸660x495
历年尿液有形成分室间质评大合辑
图片尺寸585x462
即贴即用,手机闪光灯做照明,无需电池;√ 2um光学分辨率,约放大20
图片尺寸790x1104
真正的荧光微观角度的人体皮肤细胞
图片尺寸700x700
7680*4320px发票合同问题/闪耀发光闪光光泽荧光查看作者其他作品查看
图片尺寸700x394
宝可梦剑盾——闪光细胞真可爱!
图片尺寸1564x977
iridophore -闪光细胞(虹细胞)xanthophore
图片尺寸600x356
真正的荧光小鼠神经母细胞瘤细胞系的微观角度
图片尺寸700x683
闪光细胞可见于()
图片尺寸450x300